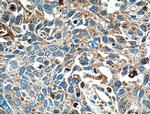
LGALS3BP Antibody in Immunohistochemistry (Paraffin) (IHC (P))

Search
Proteintech
LGALS3BP Polyclonal Antibody
{{$productOrderCtrl.translations['antibody.pdp.commerceCard.promotion.promotions']}}
{{$productOrderCtrl.translations['antibody.pdp.commerceCard.promotion.viewpromo']}}
{{$productOrderCtrl.translations['antibody.pdp.commerceCard.promotion.promocode']}}: {{promo.promoCode}} {{promo.promoTitle}} {{promo.promoDescription}}. {{$productOrderCtrl.translations['antibody.pdp.commerceCard.promotion.learnmore']}}
产品信息
10281-1-AP
种属反应
已发表种属
宿主/亚型
分类
类型
抗原
偶联物
形式
浓度
规格
纯化类型
保存液
内含物
保存条件
运输条件
产品详细信息
Immunogen sequence: LFWVWLLVA GTQGVNDGDM RLADGGATNQ GRVEIFYRGQ WGTVCDNLWD LTDASVVCRA LGFENATQAL GRAAFGQGSG PIMLDEVQCT GTEASLADCK SLGWLKSNCR HERDAGVVCT NETRSTHTLD LSRELSEALG QIFDSQRGCD LSISVNVQGE DALGFCGHTV ILTANLEAQA LWKEPGSNVT MSVDAECVPM VRDLLRYFYS RRIDITL (6-221 aa encoded by BC002403)
靶标信息
The galectins are a family of beta-galactoside-binding proteins implicated in modulating cell-cell and cell-matrix interactions. LGALS3BP has been found elevated in the serum of patients with cancer and in those infected by the human immunodeficiency virus (HIV). It appears to be implicated in immune response associated with natural killer (NK) and lymphokine-activated killer (LAK) cell cytotoxicity. Using fluorescence in situ hybridization the full length 90K cDNA has been localized to chromosome 17q25. The native protein binds specifically to a human macrophage-associated lectin known as Mac-2 and also binds galectin 1.
仅用于科研。不用于诊断过程。未经明确授权不得转售。
生物信息学
蛋白别名: 90K; Basement membrane autoantigen p105; Galectin-3-binding protein; L3 antigen; Lectin; Lectin galactoside-binding soluble 3-binding protein; mac-2 BP; Mac-2-binding protein; MAC2BP; serum protein 90K; transport and golgi organization 10 homolog B; Tumor-associated antigen 90K; unnamed protein product
基因别名: 90K; BTBD17B; CyCAP; gp90; LGALS3BP; M2BP; MAC-2-BP; TANGO10B
UniProt ID: (Human) Q08380
Entrez Gene ID: (Human) 3959